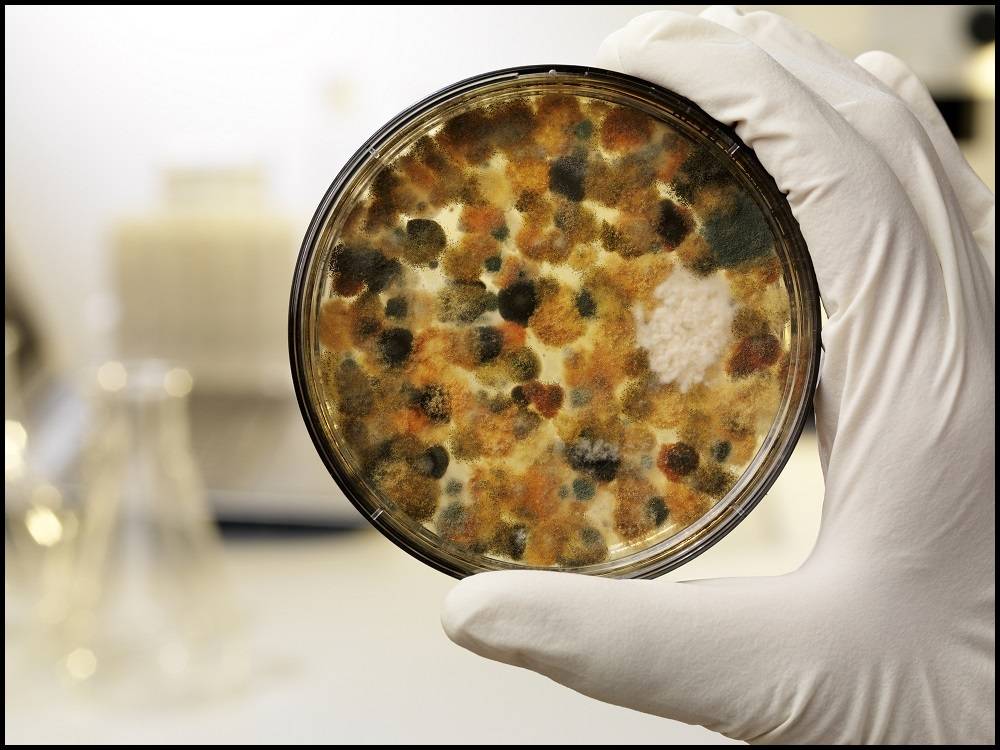
霉菌乳品种常见的酵母菌有汉氏酵母,脆壁酵母,假丝酵母,原酵母属等.

酵母菌污染

这是酵母菌污染吗?求助!
图片尺寸3024x4032
这是酵母菌污染吗?求助!
图片尺寸4032x3024
酵母菌污染-哔哩哔哩_bilibili
图片尺寸672x378
霉菌酵母菌正置培养污染,同时倒置培养的没有问题,请教怎么回事呢?
图片尺寸2336x4160
这是酵母菌污染吗?求助!
图片尺寸4032x3024
一,食品工业发酵中常见的微生物污染细菌污染:细菌是食品工业发酵中最
图片尺寸1706x884
质监局曝出这款大牌酸奶酵母菌超标370倍小区超市就有卖
图片尺寸660x404
【原创】细胞酵母污染图片 savid888 2005-04-26 22:48 关注
图片尺寸2272x1704
食品厂霉菌污染产生的源头有哪些?
图片尺寸3234x2156
霉菌乳品种常见的酵母菌有汉氏酵母,脆壁酵母,假丝酵母,原酵母属等.
图片尺寸1000x750
自然发酵所涉及的微生物主要有酵母菌,曲霉菌及乳酸菌
图片尺寸745x497
霉菌性阴道炎,这辈子还能不能治好?有一点是关键
图片尺寸1080x810
看看我这个是不是也是酵母菌污染呢?我高度怀疑是,看起来也很像呢.
图片尺寸859x638
防治鲜湿米粉中的酵母菌污染
图片尺寸1920x1080
食品生产中酵母菌超标的原因_奥克泰士_污染_消毒液
图片尺寸900x507
对多数霉菌酵母而言,超过该范围不适宜,但不排除少数适应力强的破坏
图片尺寸1280x853
天然酵母问题排除您的问题在这里已解答
图片尺寸1024x655
6)添加酵母后能利于起发,减少啤酒有害菌的污染,又能使形成的代谢产物
图片尺寸627x355
乳制品酵母菌污染怎么办?食品加工厂如何控制微生物污染?
图片尺寸2480x1076
放线菌,细菌,酵母菌和霉菌在土壤样品选择培养基上的菌落特性.
图片尺寸1200x800